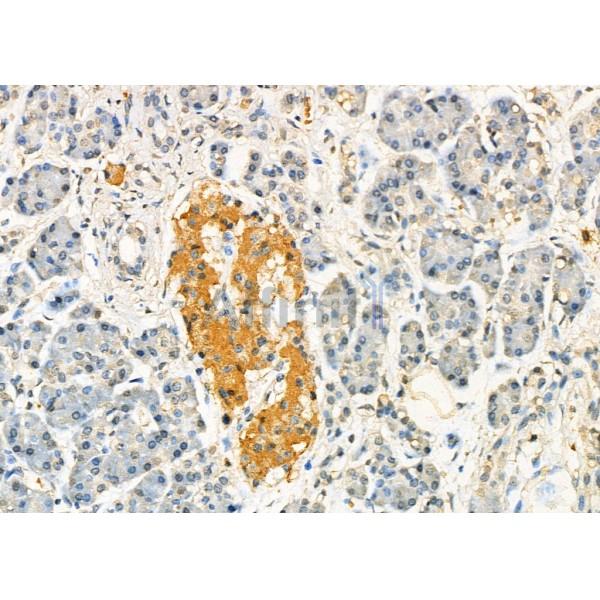
C10orf2 Antibody - DF7263 at 1/100 staining Human pancreatic cancer and adjacent nomal tissues by IHC-P.

C10orf2 Antibody - #DF7263
| Product: | C10orf2 Antibody |
| Catalog: | DF7263 |
| Description: | Rabbit polyclonal antibody to C10orf2 |
| Application: | WB IHC |
| Reactivity: | Human, Mouse, Rat |
| Mol.Wt.: | 77kDa; 77kD(Calculated). |
| Uniprot: | Q96RR1 |
| RRID: | AB_2839202 |
Related Downloads
Protocols
Product Info
*The optimal dilutions should be determined by the end user. For optimal experimental results, antibody reuse is not recommended.
*Tips:
WB: For western blot detection of denatured protein samples. IHC: For immunohistochemical detection of paraffin sections (IHC-p) or frozen sections (IHC-f) of tissue samples. IF/ICC: For immunofluorescence detection of cell samples. ELISA(peptide): For ELISA detection of antigenic peptide.
Cite Format: Affinity Biosciences Cat# DF7263, RRID:AB_2839202.
Fold/Unfold
Ataxin 8; Ataxin8; ATXN 8; ATXN8; C10 orf2; C10orf 2; C10orf2; Chromosome 10 open reading frame 2; IOSCA; mitochondrial; MTDPS7; PEO 1; PEO; PEO1; PEO1_HUMAN; PEOA3; Progressive external ophthalmoplegia 1 protein; SANDO; SCA 8; SCA8; T7 gp4 like protein with intramitochondrial nucleoid localization; T7 gp4-like protein with intramitochondrial nucleoid localization; T7 helicase-related protein with intramitochondrial nucleoid localization; T7 like mitochondrial DNA helicase; T7-like mitochondrial DNA helicase; Twinkle protein; Twinkle protein, mitochondrial; TWINL;
Immunogens
A synthesized peptide derived from human C10orf2, corresponding to a region within C-terminal amino acids.
High relative levels in skeletal muscle, testis and pancreas. Lower levels of expression in the heart, brain, placenta, lung, liver, kidney, spleen, thymus, prostate, ovary, small intestine, colon and leukocytes. Expression is coregulated with MRPL43.
- Q96RR1 PEO1_HUMAN:
- Protein BLAST With
- NCBI/
- ExPASy/
- Uniprot
MWVLLRSGYPLRILLPLRGEWMGRRGLPRNLAPGPPRRRYRKETLQALDMPVLPVTATEIRQYLRGHGIPFQDGHSCLRALSPFAESSQLKGQTGVTTSFSLFIDKTTGHFLCMTSLAEGSWEDFQASVEGRGDGAREGFLLSKAPEFEDSEEVRRIWNRAIPLWELPDQEEVQLADTMFGLTKVTDDTLKRFSVRYLRPARSLVFPWFSPGGSGLRGLKLLEAKCQGDGVSYEETTIPRPSAYHNLFGLPLISRRDAEVVLTSRELDSLALNQSTGLPTLTLPRGTTCLPPALLPYLEQFRRIVFWLGDDLRSWEAAKLFARKLNPKRCFLVRPGDQQPRPLEALNGGFNLSRILRTALPAWHKSIVSFRQLREEVLGELSNVEQAAGLRWSRFPDLNRILKGHRKGELTVFTGPTGSGKTTFISEYALDLCSQGVNTLWGSFEISNVRLARVMLTQFAEGRLEDQLDKYDHWADRFEDLPLYFMTFHGQQSIRTVIDTMQHAVYVYDICHVIIDNLQFMMGHEQLSTDRIAAQDYIIGVFRKFATDNNCHVTLVIHPRKEDDDKELQTASIFGSAKASQEADNVLILQDRKLVTGPGKRYLQVSKNRFDGDVGVFPLEFNKNSLTFSIPPKNKARLKKIKDDTGPVAKKPSSGKKGATTQNSEICSGQAPTPDQPDTSKRSK
Research Backgrounds
Involved in mitochondrial DNA (mtDNA) metabolism. Could function as an adenine nucleotide-dependent DNA helicase. Function inferred to be critical for lifetime maintenance of mtDNA integrity. In vitro, forms in combination with POLG, a processive replication machinery, which can use double-stranded DNA (dsDNA) as template to synthesize single-stranded DNA (ssDNA) molecules. May be a key regulator of mtDNA copy number in mammals.
Mitochondrion matrix>Mitochondrion nucleoid.
Note: Colocalizes with mtDNA in mitochondrial nucleoids, a nucleoproteins complex consisting of a number of copies of proteins associated with mtDNA, probably involved in mtDNA maintenance and expression.
High relative levels in skeletal muscle, testis and pancreas. Lower levels of expression in the heart, brain, placenta, lung, liver, kidney, spleen, thymus, prostate, ovary, small intestine, colon and leukocytes. Expression is coregulated with MRPL43.
Restrictive clause
Affinity Biosciences tests all products strictly. Citations are provided as a resource for additional applications that have not been validated by Affinity Biosciences. Please choose the appropriate format for each application and consult Materials and Methods sections for additional details about the use of any product in these publications.
For Research Use Only.
Not for use in diagnostic or therapeutic procedures. Not for resale. Not for distribution without written consent. Affinity Biosciences will not be held responsible for patent infringement or other violations that may occur with the use of our products. Affinity Biosciences, Affinity Biosciences Logo and all other trademarks are the property of Affinity Biosciences LTD.